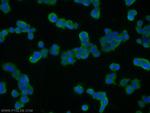
SNAP25 Antibody in Immunocytochemistry (ICC/IF)

Search
Proteintech
SNAP25 Polyclonal Antibody
{{$productOrderCtrl.translations['antibody.pdp.commerceCard.promotion.promotions']}}
{{$productOrderCtrl.translations['antibody.pdp.commerceCard.promotion.viewpromo']}}
{{$productOrderCtrl.translations['antibody.pdp.commerceCard.promotion.promocode']}}: {{promo.promoCode}} {{promo.promoTitle}} {{promo.promoDescription}}. {{$productOrderCtrl.translations['antibody.pdp.commerceCard.promotion.learnmore']}}

Please note: We are reviewing Western blot images included in the antibody testing data in our catalog, including those provided by third parties. Unless expressly labeled or annotated as “raw-unedited”, Western blot images included in the antibody testing data in our catalog may have been edited, optimized or otherwise adjusted for presentation.
产品信息
14903-1-AP
种属反应
已发表种属
宿主/亚型
分类
类型
抗原
偶联物
形式
浓度
规格
纯化类型
保存液
内含物
保存条件
运输条件
产品详细信息
Immunogen sequence: MAEDADMRN ELEEMQRRAD QLADESLEST RRMLQLVEES KDAGIRTLVM LDEQGEQLDR VEEGMNHINQ DMKEAEKNLK DLGKCCGLFI CPCNKLKSSD AYKKAWGNNQ DGVVASQPAR VVDEREQMAI SGGFIRRVTN DARENEMDEN LEQVSGIIGN LRHMALDMGN EIDTQNRQID RIMEKADSNK TRIDEANQRA TKMLGSG (1-206 aa encoded by BC010647)
靶标信息
SNAP25 is a t-SNARE involved in the molecular regulation of neurotransmitter release. It may play a role in the synaptic function of specific neuronal systems. SNAP25 associates with proteins involved in vesicle docking and membrane fusion. It also regulates plasma membrane recycling through its interaction with CENPF. Mutations in the gene can results in myasthenic syndrome.
仅用于科研。不用于诊断过程。未经明确授权不得转售。
生物信息学
蛋白别名: ALMS1; blind drunk; CG17676; CG17884; CG40452; Dmel CG40452; Dmel_CG40452; FLJ23079; HGNC:11132; HUMSNAP25B(F); resistance to inhibitors of cholinesterase 4 homolog; SNAP 25; SNAP-25; snp25; SUP; Super protein; Synaptosomal-associated 25 kDa protein; Synaptosomal-associated protein 25; synaptosomal-associated protein, 25 kDa; synaptosomal-associated protein, 25kDa; synaptosome associated protein 25kDa; unnamed protein product
基因别名: bA416N4.2; Bdr; CMS18; DEE117; dJ1068F16.2; GENA70; RIC-4; RIC4; SEC9; SNAP; SNAP-25; SNAP-25a; SNAP-25B; SNAP25; sp; SUP
UniProt ID: (Rat) P70557, (Mouse) P60879
Entrez Gene ID: (Human) 6616, (Rat) 25012, (Mouse) 20614




